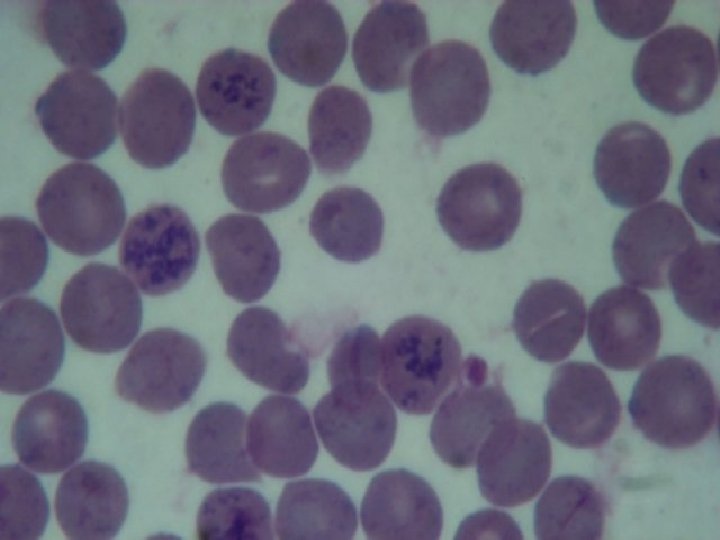
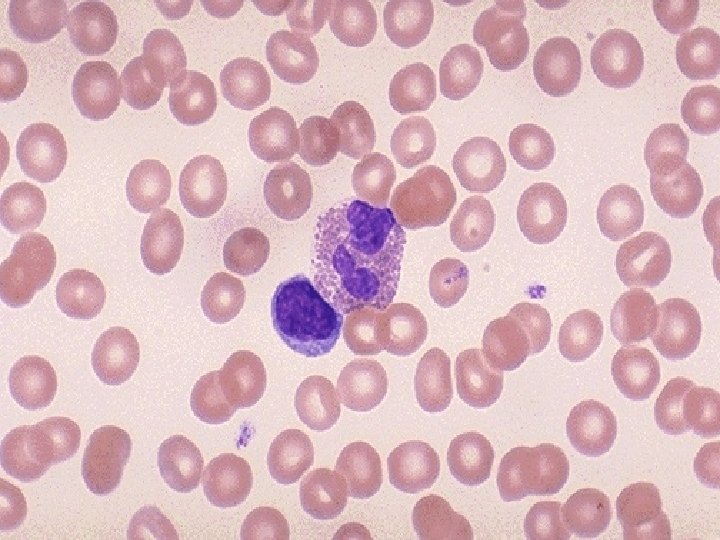

RADIAN POKOZEN KREVNCH BUNK I Cl Modelovn akutn

RADIAČNÍ POŠKOZENÍ KREVNÍCH BUNĚK I. Cíl: Modelování akutní nemoci z ozáření I. stupně - krevní formy změny parametrů KO + diferenciál Ø změny hmotnosti vybraných orgánů Ø změny tělesné hmotnosti Ø

Ionizující záření způsobuje ionizaci elektroneutrálních atomů a molekul (přímo nebo sekundárně vzniklými elektrony): Ø elektromagnetické záření ( a RTG) Ø korpuskulární záření (heliová jádra) (elektrony) mezony neutrony

Elektromagnetické záření: - schopno pronikat do hloubky a ionizovat při průchodu tkáněmi Korpuskulární záření: - průnik je limitován nábojem, rychlostí a hmotností částic

Dávky záření Velikost účinku: absorbovaná dávka (J/kg) - gray (Gy) 1 Gy = 100 rad Ø Různá biologická účinnost dávkový ekvivalent (J/kg) – sievert (Sv) Ø Q - faktor kvality záření: gama: Q=1 neutrony: Q=10 částice: Q=20 Ø

Teorie o účincích ionizujícího záření 1. Zásahová teorie Ø Ø v každé buňce je citlivý terč, jehož zasažení vede jejímu poškození exponenciální závislost mezi efektem a dávkou = jeden terč sigmoidální závislost = více terčů (více zásahů) N (přežívajících) = n N 0 e-v. D


2. Teorie nepřímého účinku (radikálová) Záření vyvolává přímo či nepřímo Ø Ø tzv. excitaci molekul (přechod elektronů na vyšší energetické hladiny) uvolněné protony pronikají do protoplazmy a dochází ke vzniku iontových párů reagují hlavně s vodou vznik volných radikálů (. H) a (. OH) při interakcích vznikají reaktivní formy H 2 O 2 a (. HO 2) interakce s nukleovými kyselinami, enzymy, membránami poškození DNA

3. Teorie duálové radiační akce Předpoklady: Ø Ø prvotní vyvolání sublézí - počet je přímoúměrný sdělené energii, odpovídají tzv. absorpčním aktům (diskretním interakcím částic záření s látkou) primární biologická léze vzniká kombinací dvou sublézí efekt = a. D + b. D 2 + c relativní biologická účinnost: poměr efektivní dávky řídce a hustě ionizujícího záření


4. Molekulárně biologická teorie Ø Ø poškození je kombinací dvou primárních dějů - buď v průběhu dráhy jedné částice - nebo je každý vázán na průchod jiné částice přesně definuje terč vliv biochemických procesů a stavu buňky (reparační mechanizmy) manifestace efektu není s poškozením vázána deterministicky, ale pravděpodobnostně N = D + D 2

Účinky záření na buňku Ø buňky zmírají mitotickou, postmitotickou smrtí (x lymfocyty, zárodečné buňky) Ø průměrná letální dávka je několik Gy (x stovky Gy pro biochemickou smrt) Ø ústřední poruchou - poškození DNA (změny membrán, zpomalení průchodu buněk jednotlivými fázemi cyklu - využití v radioterapii) Ø nemusí způsobit zánik buňky - změny genetické (genové x chromozomové mutace) (gametické x somatické mutace)

Radiosenzitivita buněk Ø přítomnost kyslíku, endogenních thiolů (-SH zvl. glutathiol) v okolí DNA - hypoxie = cca 3 x radiorezistentnější Ø výkonnost enzymatických reparačních mechanizmů Ø fáze buněčného cyklu (nejcitlivější v mitóze, rezistence v pozdní S-fázi)

Účinek ionizujícího záření na tkáně Ø nutná znalost cytokinetiky tkáně - rychlost vtoku buněk (trvání buněčného cyklu a růstová frakce) - odtok buněk (ztráty) Ø čas potřebný k tomu, aby se projevilo poškození, závisí na zmíněných cytokinetických parametrech obvykle je určitá funkční rezerva

Hematologické změny u pacientů po dávce 4. 3 Gy


Účinky ionizujícího záření na člověka Ø nestochastické: - akutní nemoc z ozáření - akutní lokalizované poškození - poškození plodu in utero - pozdní nenádorová poškození Ø stochastické - zhoubné nádory - genetické změny


Akutní nemoc z ozáření (akutní postradiační syndrom) následkem ozáření celého těla či jeho podstatné části Ø 3 formy - liší se klinicky i mortalitou Ø všechny fáze mají prodromální příznaky, období latence, období vystupňovaných příznaků a pokud nemocný přežije období rekonvalescence Ø délka latence i způsob manifestace - závisí na velikosti ozáření Ø

Neurovaskulární syndrom vznik po dávce několika desítek Gy ( 50 Gy) Ø krátká prodromální fáze (nauzea, zvracení) Ø rychlý nástup letargie, apatie, ataxie, záchvaty (grand mal) Ø rezistentní hypotenze, arytmie, šok Ø smrt v rozmezí 24 - 48 hod Ø

Gastrointestinální syndrom Ø Ø Ø vznik po dávce kolem 10 Gy prodromy: anorexie, nauzea, zvracení latence 3 - 7 dní Úporné zvracení, průjmy, známky dehydratace (dány úvodní toxémií z nekróz tkání a pokračující atrofie střevní sliznice) zmenšení plazmatického volumu, oběhové selhání terminálně - nekrózy střevní sliznice, masívní ztráty plazmy do střeva, smrt

Hemopoetický syndrom Ø Ø Ø po dávkách 3 - 5 Gy (hraničně po dávkách 1 - 2 Gy) prodromy: anorexie, nauzea, meningeální dráždění, zarudnutí kůže a spojivek (mizí do 36 hod) období latence (1 - 2 týdny) známky porušené obranyschopnosti a krvácivé projevy - sepse, krvácení, poškození sliznic fáze rekonvalescence 4. - 8. týden (úprava do roka)

Laboratorní nálezy Ø okamžitá lymfopenie (extrémní citlivost intermitotická smrt, glukokortikoidy) Ø zmnožení neutrofilů (obraz zánětlivé reakce s vyplavením granulocytů ze dřeně) Ø pomalejší nástup trombocytopenie Ø ještě pomalejší pokles Ery, Hb, Htk. . .

Praktikum potkani kontrolní a dvě skupiny ozářených (po 3 a 20 dnech) Ø zvážení zvířete (v éterové anestezii) Ø odběr krve ze srdeční komory Ø 2 nátěry Ø zbytek krve do zkumavky Ø odběr a zvážení slezin Ø

Náš úkol Ø Stanovení: - počtu erytrocytů - množství hemoglobinu - hematokritu - počtu leukocytů - počtu trombocytů Ø Příprava periferního nátěru: - pro počítání diferenciálu - pro počítání retikulocytů

Stanovení počtu Ery Ø do baničky s Hayemovým roztokem 25 l krve Ø 2 - 3 minuty protřepáváme Ø naplníme Bürkerovu komůrku Ø počítáme ve 20 obdélnících a vypočítáme: T=Σ 20 x 10 000 (počet/ l)

Stanovení hemoglobinu Ø hemiglobinkyanidová metoda (oxidace roztokem ferrikyanidu draselného) Ø 25 l krve do roztoku (dle Drabkina) Ø 10 minut necháme stát Ø měříme absorbanci v kyvetě proti Drabkinově roztoku Ø z kalibrační křivky odečteme konc. v g/l

Stanovení hematokrytu Ø naplníme kapiláry délky 75 mm krví Ø centrifugujeme Ø odečteme 3 min při 100 000 g pomocí odečítacího zařízení

Počítání leukocytů baničky s 475 l Türkova roztoku 25 l krve Ø 2 – 3 min necháme stát Ø protřepeme a naplníme Bürkerovu komůrku Ø počítáme v 50 čtvercích a vypočítáme T=Σ 50 x 100 (počet/ l) Ø do

Počítání destiček baničky s prokainem - 25 l krve Ø 20 minut čekáme na hemolýzu erytrocytů Ø protřepeme a naplníme Bürkerovu komůrku Ø počítáme ve 20 obdélnících a vypočítáme T=Σ 20 x 1000 (počet/ l) Ø u člověka 150 - 300 tis. / l, u potkana cca 600 tis. / l Ø do

RADIAČNÍ POŠKOZENÍ KREVNÍCH BUNĚK II. Cíl: Pokračováním praktika z minulého týdne je zhodnocení periferního krevního nátěru

1. Počítání retikulocytů Ø Ø Ø mladé erytrocyty - nelze prokázat v nativním stavu brilantkresylová modř v erytrocytu se objeví modrá vlákna a zrna (substantia reticulofilamentosa - zbytky ribonukleové kyseliny v plazmě) podle množství zrn s sítě se dále rozeznávají méně či více zralé retikulocyty v krvi u člověka je: 0. 5 -1. 5% (5 -15%O) retikulocytů

Hodnocení Ø počítáme s imerzí, 100 násobné zvětšení spočítá se 1000 ery a zaznamená se, kolik je retikulocytů Ø Norma: kolem 20 %O retikulocytů v krvi potkana Ø počtu: zvýšená krvetvorba (regenerace) ery počtu: útlum tvorby erytrocytů

2. Diferenciální rozpočet bílých krvinek Ø určuje se v nátěru obarveném Leukodifem Ø Počet jednotlivých druhů se určuje nejméně na 100, přesněji na 200 leukocytů počítá se procentuelní zastoupení

Prohlížení nátěru Nátěr - prohlížet meandrovitě rozložení leukocytů v nátěru není stejnoměrné větší leuko : na okrajích (mono, Eo) Ø menší leuko: ve středu (lymfo) Ø

Diferenciální rozpočet u laboratorního potkana Ø Počet leukocytů. . . cca 12. 5 tis. mm-3 - neutrofilní granulocyty 18 - 36% - eosinofilní granulocyty 1 - 4% - bazofilní granulocyty 0 - 1% - lymfocyty 62 - 75% - monocyty 1 - 6%

Myeloická vývojová řada Ø Myeloblast Ø Promyelocyt (objeví se granula) Ø Myelocyt (granula jasně diferencovaná) Ø Metamyelocyt Ø Tyčka (nesegmentované jádro) Ø Segment (členěné jádro)




Monocytární vývojová řada Ø Monoblast Ø Promonocyt Ø Monocyt - velká buňka, bohatá na plazmu, jádro s řídkou vláknitou stavbou, chudé na chromatin, tvar podkovy, fazole nebo laločnaté uložené excentricky




Lymfatická vývojová řada Lymfoblast Ø Prolymfocyt Ø Lymfocyt - malý: 80 -90% všech lymfo plazma tvoří jen úzký bledě modrý lem kolem jádra (srpek měsíce) jádro okrouhlé, tmavé - velký: více plazmy, méně hutné jádro Ø

Závěr: výsledky vyšetření periferní krve (všech testů a hodnot) zaznamenat do tabulky Ø porovnat rozdíly mezi skupinami ozářených zvířat s různým časovým odstupem (3, resp. 20 dní po dávce 4 Gy celotělově) a skupinou kontrolní Ø diskuse výsledků Ø
- Slides: 50